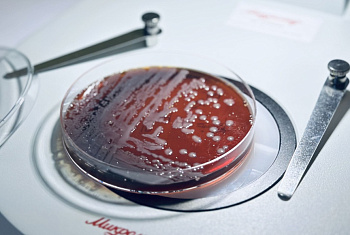
Лаборатория преодоления микробной резистентности

- Главная
- Об институте
- Лаборатории
- Лаборатория простых систем
- Лаборатория системного анализа микроорганизмов
- Лаборатория мультиомиксных исследований
- Лаборатория дизайна искусственных ферментов
- Лаборатория инфекционной иммунологии
- Лаборатория вирусных систем
- Лаборатория математической биологии и биоинформатики
- Лаборатория цифрового мониторинга здоровья человека
- Лаборатория преодоления микробной резистентности
- Лаборатория экспериментальных моделей
- Лаборатория биоэлектрохимии
- Лаборатория микро- и нанофлюидики
- Лаборатория биомолекулярного компьютерного дизайна
- Лаборатория эпидемиологии человека
- Наши публикации
- ЦГИМУ
- Контакты
- Микробиом приглашает к разговору
- Календарь конференций
- Итоговые конференции НИИ СБМ